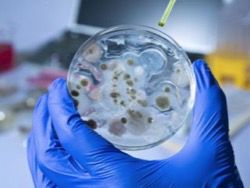

Физиолог Марьяна Безруких о пользе и вреде цифровых учебников
Российские школы официально перешли на электронные книги. В соответствии с приказом Минобрнауки в федеральный перечень учебников могут попасть только те, которые имеют цифровые копии. Однако, по мнению

Житель Китая продемонстрировал чудеса силы воли, похудев более чем на 13 кг всего за полтора месяца. На такой поступок его толкнуло желание помочь собственной семимесячной дочери.
У ребенка возникли проблемы со здоровьем, ей требовалась пересадка печени. Однако врачи

Есть вероятность того, что препарат будет включен в в открытое сравнительное исследование с разработками других стран
Российская вакцина против вируса Эболы будет официально представлена на исполкоме ВОЗ 25-30 января в Женеве. Об этом сообщила министр здравоохранения

Вот честно, не хотел писать на эту тему. Потому что и так меня на российское телевидение чаще приглашают в качестве того, кто пишет про эпидемии и американские биолаборатории, чем в качестве экономиста или политолога (там у них своя мафия).
Но, видимо, всё же придётся

Многие хотели бы есть лишь здоровую пищу, но при этом испытывают серьезные затруднения, когда дело доходит до изменения диеты.
Однако нам уже довольно давно известно, что изменение времени приема пищи отражается на весе и метаболизме. Как минимум, именно так происходит у

Между употреблением кофе и размером женской груди существует взаимосвязь, заявили шведские ученые. Из-за частого употребления бодрящего напитка размер бюста уменьшается.
Исследователи провели эксперимент, в котором приняли участие около 300 женщин. Они употребляли
Вирусолог Айра Лонджини, работавший над созданием вакцины от лихорадки Эбола в Институте новых патогенов университета Флориды (США), опроверг слова президента РФ Владимира Путина о том, что Россия зарегистрировала высокоэффективное лекарство против африканской

Власти Киева с субботы, 16 января, вводят в учреждениях образования и здравоохранения города карантин для предотвращения распространения заболеваемости гриппом и ОРВИ. Также ограничения распространятся на проведение публичных мероприятий. Об этом заявил мэр

Немецкие исследователи создали внешний двигатель, толкающий сперматозоид в нужном направлении. Исследование опубликовано в журнале Nano Letters, а краткий пересказ — на сайте N+1.
Группа ученых из Хемницкого технического университета и Лейбницкого института

Доктор медицинских наук Морган Грамс из университета Джона Хопкинса в Балтиморе утверждает, что популярные таблетки от изжоги повышают риск развития хронического заболевания почек. Такие результаты показало исследование, проведенное группой учёных под его